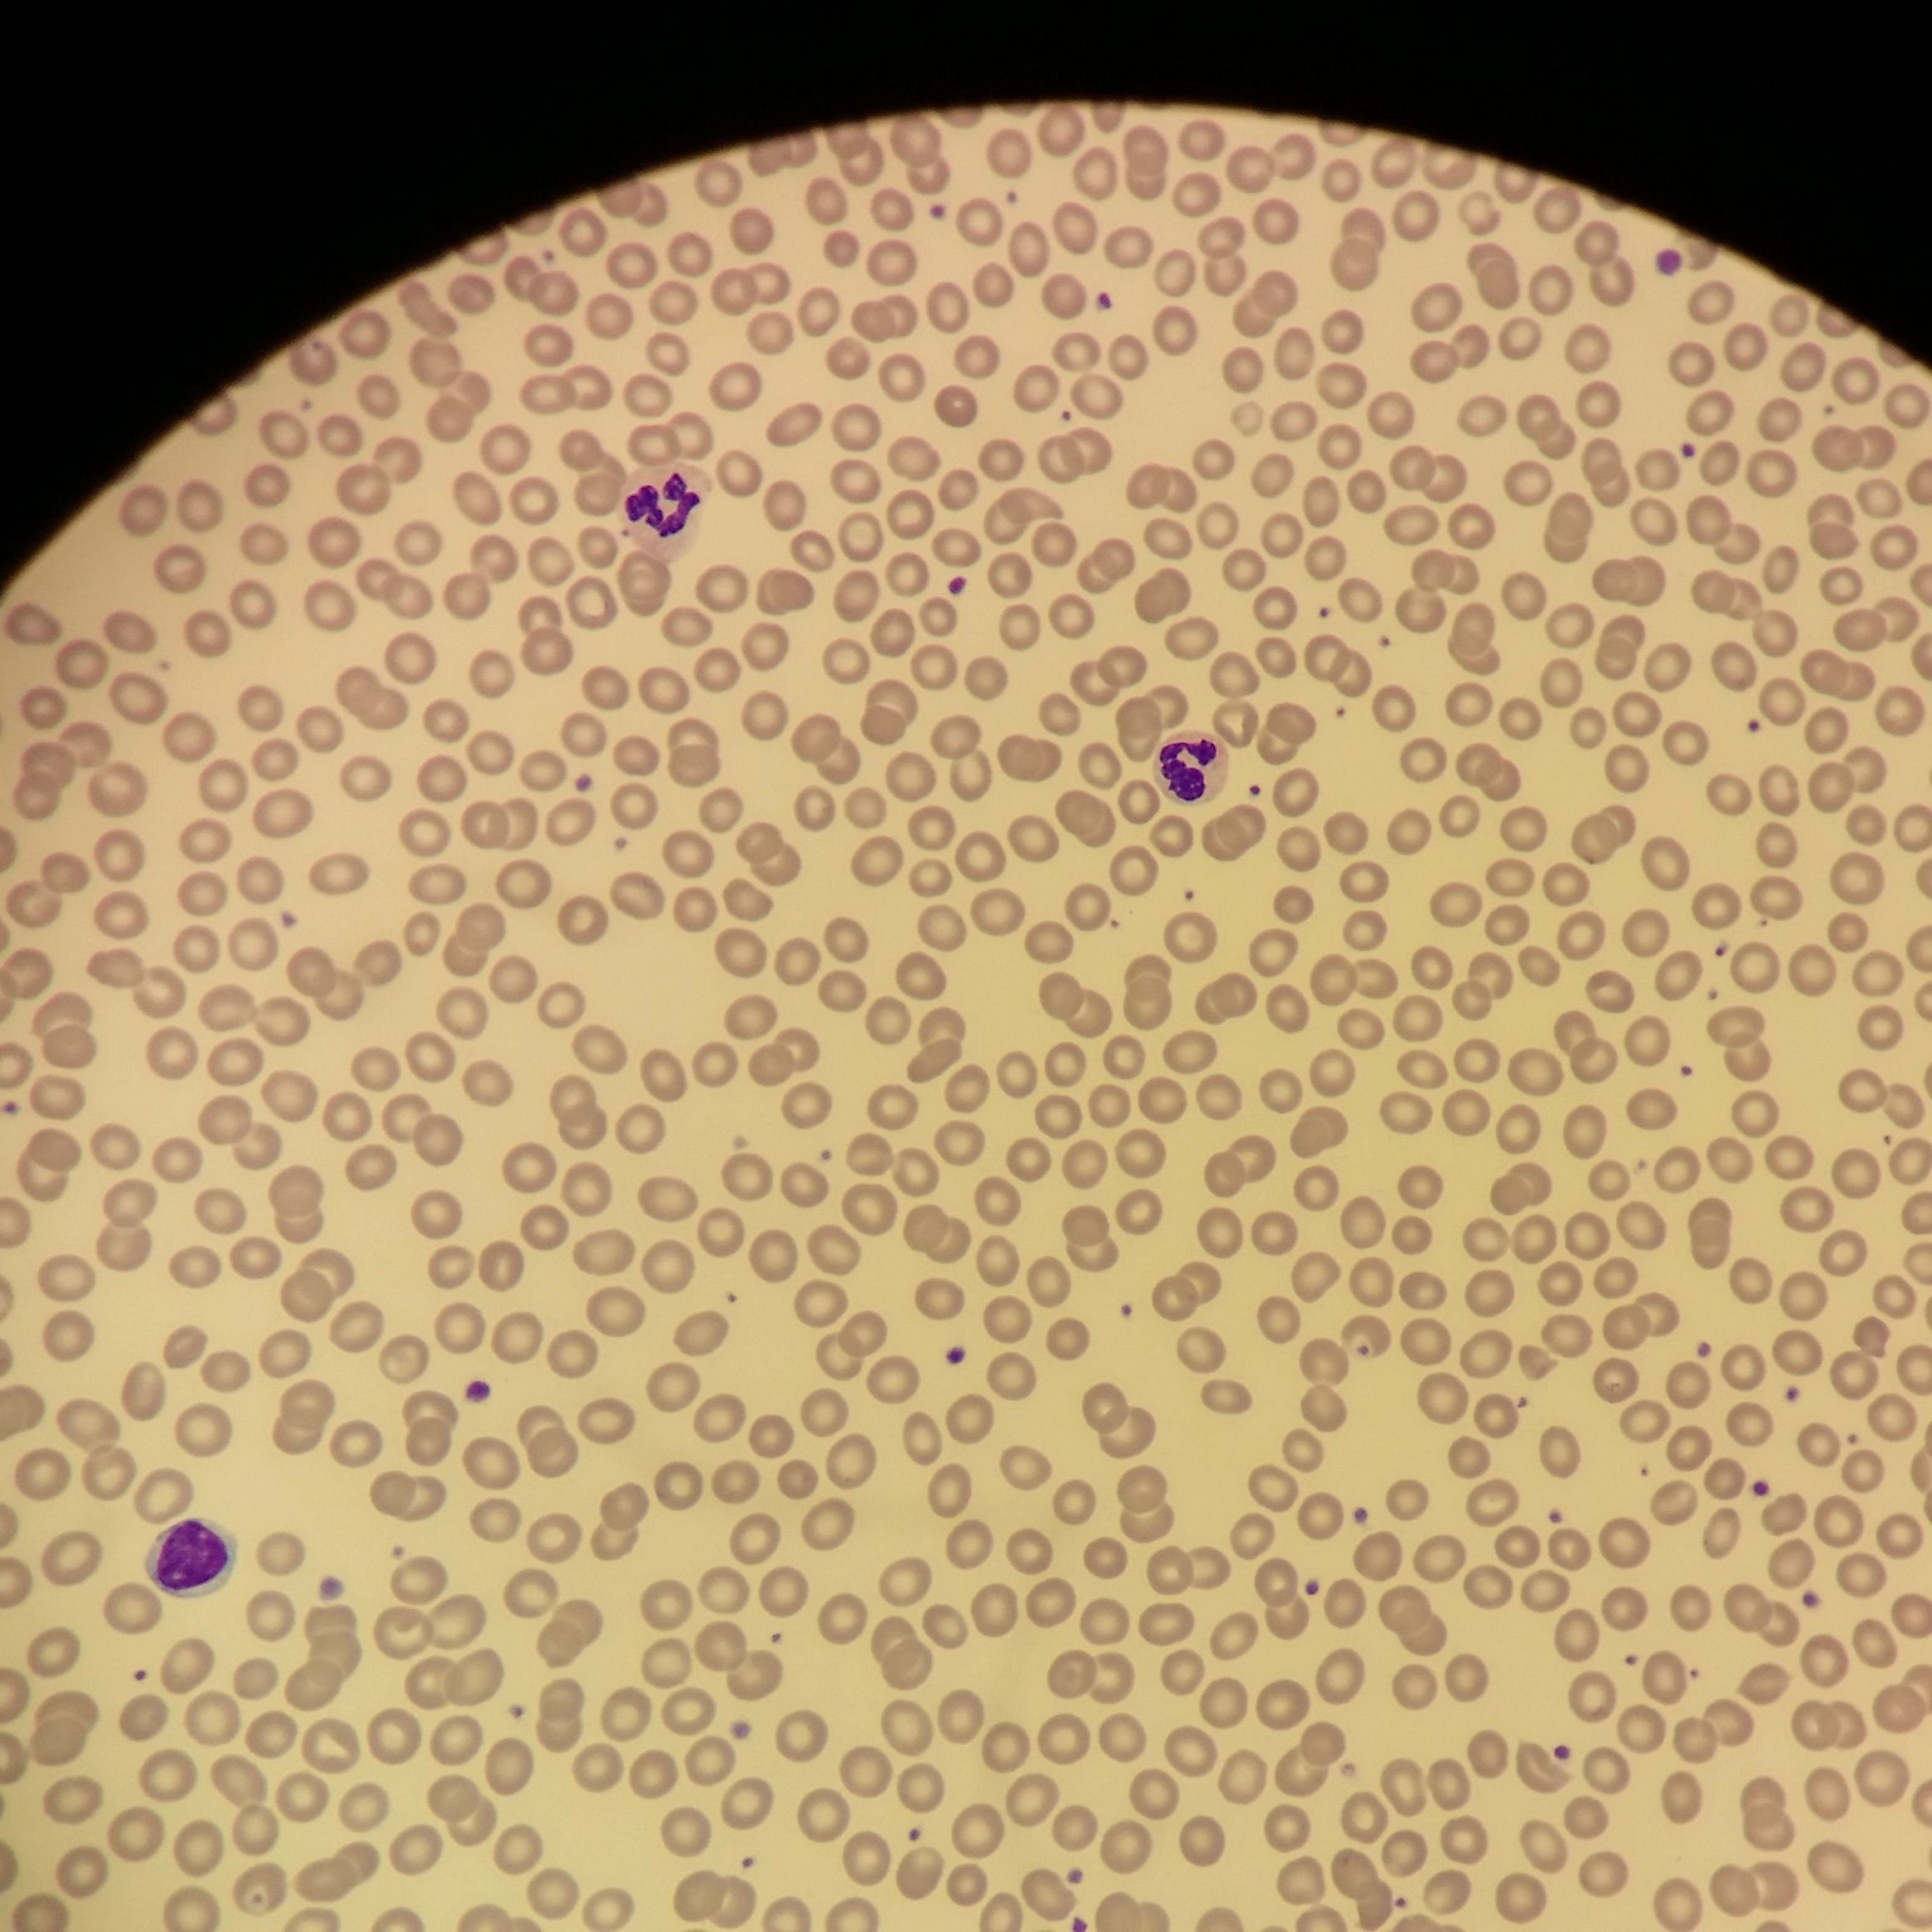
ingredient

Classical Nalpamaradi Mukhalaya Face Oil
Dry, Scaly, Sensitive, Allergic Skin
Ref: Sahasra yoga, Tailayoga prakaran, 26



Delhi, NCR, Bangalore
2-5 Days After Shipment
Pan India
4-5 Days After Shipment
Free shipping above ₹339
Cash on delivery available at ₹20 COD charges
Additional Information
MANUFACTURED AND MARKETED BY
NaturoHabit Private Limited GP-26, Sector 18, Gurugram, Haryana - 122015
COUNTRY OF ORIGIN
India
NODAL OFFICER DETAIL
Madhuri Pandey madhuri@nathabit.in
Delhi, NCR, Bangalore
2-5 Days After Shipment
Pan India
4-5 Days After Shipment
Free shipping above ₹339
Cash on delivery available at ₹20 COD charges
Additional Information
MANUFACTURED AND MARKETED BY
NaturoHabit Private Limited GP-26, Sector 18, Gurugram, Haryana - 122015
COUNTRY OF ORIGIN
India
NODAL OFFICER DETAIL
Madhuri Pandey madhuri@nathabit.in
These Are the Pure Drops of Calm & Strength Revival

Click to Know More
It repairs skin rapidly by boosting collagen, lipids & cell renewal
This deeply restorative oil accelerates skin healing by stimulating collagen production, lipid replenishment, and cellular regeneration. Haridra (Turmeric) works as a powerful antioxidant and anti-inflammatory, while Nyagrodha, Plaksha, and Aswatha activate tissue repair and restore moisture balance. Together, they rebuild damaged skin, improving resilience, texture, and elasticity.
It strengthens the barrier, relieving dryness, eczema & irritation
Targeting the root of skin sensitivity, this blend reinforces the epidermal barrier and reduces inflammation. Ficus herbs (Nyagrodha, Udumbara) and Chandana (Sandalwood) deliver astringent and calming actions, while Haridra soothes inflammatory conditions like eczema and scaling. Sesame oil’s essential fatty acids lock in moisture, prevent TEWL (trans-epidermal water loss), and protect against external irritants.
It detoxifies skin & calms inflamed, rash-prone tissues
This oil purifies at both cellular and circulatory levels, helping flush out toxins that lead to rashes, inflammation, and dermatitis. Choraka and Usheer (Vetiver) bring powerful cooling and detoxifying actions that calm overheated, stressed skin. Simultaneously, it fortifies cell membranes, improving the skin’s natural defense and reducing flare-ups.
It restores natural moisture factors & deep hydration for lasting softness
By enhancing the skin’s ability to produce and retain Natural Moisturising Factors (NMFs), this oil transforms rough, flaky skin into soft, supple texture. Sesame Oil nourishes deeply, restoring lost oils and lipids, while herbs like Usheer support hydration, calm tissues, and relieve chronic dryness. Skin stays plump, hydrated, and comforted.
What Makes Nalpamaradi Ultra-potent?
Elixir for Strong, Calm Skin
✓
Flavonoid & fatty acid–rich herbs strengthen barrier and cell walls.
✓
Kwath extracts actives by reducing a 16:1 decoction to 1/8th.
✓
Herbal phytoconstituents are preserved under controlled conditions.
What’s Inside the Bottle?
Full Ingredient List: Check More Info for Full Ingredient List.
Still Thinking Why You Should Pick Mukhalaya?
Elixir of Radiant Youth!
✓
So that every layer gets fed, repaired, and radiates deep, lasting glow.
✓
So that your skin blocks daily damage before it even begins.
✓
So that youth stays locked in - firm, smooth, and evenly toned.
✓
So that it stays so soft and plump, it feels newborn again.
Recognize Authentic Nalpamaradi Oil
Authentic Nalpamaradi
Pseudo Nalpamaradi
Processing
Authentic viddhis as per scriptures to maximise potency
Minimal or none, due to cost & meticulosity involved
Formulation & Ingredients
High-grade. No dilution
Diluted with low-cost paraffin, mineral, & vegetable oils
Appearance
Red-golden & turbid due to herbal fragments
Transparent, less herb activity, yellow or brown color
Smell
Light aroma of base oils
Strong smell of fragrances
Preservatives
Required, as full process not followed
Usage
Caution
Suitable for
Season
For all seasons. In summer & humid conditions, use less quantity of Mukhalaya & more Flora Jal or water, during application.
Skin Types
For all: Oily, normal, combination, dry & sensitive skin.
Additional Moisturisation
No additional moisturiser or serum required. If preferred, you may apply a light moisturiser before the Mukhalaya. But avoid heavy butter based moisturisers.
Pre-makeup
Can be used as it is an excellent pre-makeup skin protector.
Skin Sensitivity
A few skin types may feel a little tingling or burning sensation; it’s just your skin getting used to herbs that clears skin. After a few uses, you'll not experience the sensation.
Why make Mukhalaya Oiling a Habit

Click to Know More
Rebuilds the Skin Barrier & Seals in Moisture
Face oiling strengthens the skin’s natural barrier with fatty acids like linoleic and oleic acid, helping prevent water loss and shield against damage. In Ayurveda, this nourishing action—Snigdhata—soothes dryness (Vata dosha) and supports Rasadhatu (plasma), keeping skin soft and resilient.
Enhances Microcirculation & Detox Pathways
Oiling with massage enhances blood flow and lymphatic drainage, delivering nutrients and flushing toxins. Ayurveda sees this as opening Srotas (channels) and moving Prana (life energy), resulting in brighter, clearer, more energized skin.
Deeply Nourishes & Promotes Cellular Repair
Plant oils carry vitamins and antioxidants that fuel cell renewal, repair damage, and support collagen. In Ayurveda, this is Rasayana therapy—nourishing from within (Dhatu Pushti) for lasting vitality and youthful skin.
Calms Inflammation & Soothes Sensitive Skin
Oils rich in anti-inflammatory compounds (like rosehip and turmeric) calm reactive skin. Ayurveda uses cooling oils to balance Pitta (heat and inflammation), easing redness, acne, and irritation.
Prevents Premature Aging & Boosts Skin Resilience
Facial oils fight free radicals, maintain hydration, and protect collagen—slowing signs of aging. Ayurveda uses oiling (Snehan) to counter Vata-driven aging and preserve Ojas (vital energy), promoting firmer, stronger skin.
Restores Natural Radiance & Harmonizes Internal Balance
Face oils smooth skin, improve hydration, and enhance natural light reflection. Ayurveda calls this Kanti or Tejas—a glow that comes from balanced doshas and well-nourished skin, inside and out.
Unmissable Moments for These Drops
More Information
Full Ingredient List
Storage & Expiry
Storage
Store airtight away from direct sunlight.
Net Quantity
30 ml
Expiry
Use within 12 months of Mfg. Date.
Pre-Oiling Hydration
What Makes Derma & Cells Weak?
The Science Behind Dry/ Sensitive Skin

Click to Know More
Compromised Skin Barrier – The Core of Dryness and Sensitivity
The stratum corneum, or outermost layer of the skin, is held together by lipids like ceramides, cholesterol, and fatty acids, forming a tight “brick-and-mortar” structure. In dry or sensitive skin, this lipid matrix becomes depleted, allowing trans-epidermal water loss (TEWL) and the entry of irritants. Without this protective shield, skin becomes both dehydrated and reactive—feeling tight, flaky, or burning even with mild products.
Lower Natural Moisturizing Factor (NMF) – The Inner Drought
The skin naturally produces Natural Moisturizing Factor (NMF)—a blend of amino acids, lactic acid, urea, and PCA—that draws moisture from the atmosphere and deeper layers to hydrate cells. In dry or sensitive skin, NMF levels are significantly lower due to genetics, age, or harsh cleansing. This leads to reduced water retention and internal dehydration, even if the skin looks oily. NMF-boosting ingredients help increase internal hydration and reduce tightness, flakiness, and micro-irritation.
Hyperactive Immune Response – Why Sensitive Skin Overreacts
Sensitive skin is often characterized by an exaggerated immune response to minor stimuli—like fragrance, alcohol, or temperature shifts. The skin releases pro-inflammatory cytokines leading to redness, stinging, or even itching. This inflammation further weakens the barrier, creating a vicious cycle. Calming actives help suppress inflammatory signals, reduce histamine activity, and promote a return to homeostasis.
pH Imbalance – The Acid Mantle That Keeps Sensitivity in Check
Healthy skin maintains a slightly acidic pH (around 4.7–5.5) which inhibits pathogen growth and supports barrier function. When the pH rises—due to alkaline cleansers, hard water, or over-exfoliation—the acid mantle is disrupted, encouraging microbial imbalances and barrier thinning. Sensitive skin often reflects this pH imbalance as it becomes more prone to irritation. Skincare for this type should avoid soaps and include pH-balanced formulas to help rebalance and fortify the skin's ecosystem.
Reduced Sebum Production – Starving Skin of Lipid Support
In dry skin, low sebum production means fewer protective lipids, which allows more TEWL and increases surface sensitivity to wind, detergents, and pollution. Replacing this natural oil layer with non-comedogenic, skin-identical lipids like jojoba oil restores lipid equilibrium and helps seal in moisture and calm without triggering breakouts or congestion.
Environmental Sensitizers – The Daily Assault on Compromised Skin
Dry and sensitive skin types are highly reactive to UV exposure, pollution, temperature extremes, and blue light, all of which damage skin proteins, lipids, and DNA. These triggers increase oxidative stress and barrier inflammation, making skin even more fragile. Antioxidants offer both protection and inflammation control. For sensitive skin, shielding is as important as repairing—preventing exposure is key to calming sensitivity at its root.
Build Your Own Regime to Strong, Calm Skin
Natural Lovers Also Buy!
Read & Know More!
Other Products in this range
Latest from our Ayurvedic Kitchen
Explore our other Categories
We hope you'll like them
Recently Viewed
Continue where you left off

Classical Nalpamaradi Mukhalaya Face Oil